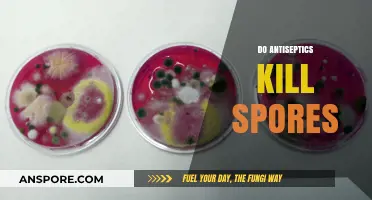
Do Antiseptics Kill Spores? Unraveling Their Effectiveness Against Spores

Amanita mushrooms, known for their striking appearance and diverse species, are often studied by mycologists and enthusiasts alike. One common method to identify these fungi is by examining their spore prints, which involve placing the cap of the mushroom on a piece of paper or glass to capture the spores released from the gills. The question of whether Amanita mushrooms drop spore prints is particularly relevant, as it provides valuable information about their reproductive mechanisms and taxonomic classification. By analyzing the color, shape, and pattern of the spore print, researchers can differentiate between various Amanita species, some of which are edible, while others are highly toxic. Understanding this process not only aids in identification but also highlights the fascinating biology of these iconic mushrooms.
Explore related products
What You'll Learn
- Spore Print Color: Amanita species vary; colors range from white to brown, aiding identification
- Collection Method: Use glass or foil to capture spores overnight for accurate prints
- Identification Tips: Spore print color is key for distinguishing Amanita from other fungi
- Environmental Factors: Humidity and temperature affect spore release and print clarity
- Toxicity Warning: Always verify species; some Amanita are deadly despite spore print similarities

Spore Print Color: Amanita species vary; colors range from white to brown, aiding identification
Amanita mushrooms, with their diverse and often striking appearances, present a unique challenge for foragers and mycologists alike. One of the most reliable methods to identify these species is through their spore print color, which varies significantly across the genus. Spore prints are created by placing the cap of a mushroom gill-side down on a piece of paper or glass, allowing the spores to drop naturally over several hours. For Amanita species, this process reveals a spectrum of colors ranging from white to brown, each hue serving as a diagnostic tool for precise identification.
Analytically, the spore print color of Amanita mushrooms is a direct result of their spore morphology and chemistry. For instance, *Amanita muscaria*, the iconic red-and-white fly agaric, produces a white spore print, while *Amanita phalloides*, the deadly death cap, yields a white to creamy-yellow print. These colors are not arbitrary; they reflect the species’ evolutionary adaptations and ecological roles. By examining spore print color alongside other characteristics like cap color, gill structure, and habitat, one can narrow down the identification with greater accuracy. This method is particularly useful in the field, where immediate results are needed.
Instructively, creating a spore print for Amanita species is a straightforward yet critical skill for anyone studying fungi. Begin by selecting a mature specimen with well-developed gills. Place the cap gill-side down on a piece of white paper or glass for light-colored spores, or dark paper for white spores, to ensure contrast. Cover the cap with a bowl or glass to maintain humidity and prevent air currents from dispersing the spores. After 6–12 hours, carefully lift the cap to reveal the spore print. Note the color and uniformity, as these details can distinguish between similar species. For example, a pure white print may indicate *Amanita ocreata*, while a pale brown print could suggest *Amanita rubescens*.
Persuasively, the importance of spore print color in Amanita identification cannot be overstated, especially given the genus’s inclusion of both edible and highly toxic species. Misidentification can have severe, even fatal, consequences. For instance, the white spore print of *Amanita bisporigera* contrasts with the cream-colored print of *Amanita citrina*, despite their similar appearances. This distinction is crucial, as the former is deadly, while the latter is mildly toxic. By prioritizing spore print analysis, foragers can mitigate risks and build confidence in their identifications. It is a small step that yields significant safety benefits.
Descriptively, the range of spore print colors in Amanita species is as fascinating as it is functional. Imagine a palette spanning from the pure, snowy white of *Amanita virosa* to the warm, earthy brown of *Amanita fulva*. Each shade tells a story of the species’ biology and ecology, from spore dispersal mechanisms to habitat preferences. For the observant forager, these colors are not just identifiers but windows into the intricate world of fungi. By appreciating this diversity, one gains a deeper understanding of the Amanita genus and its place in the natural world.
Can Spores Survive in Desert Conditions? Exploring Microbial Resilience
You may want to see also

Collection Method: Use glass or foil to capture spores overnight for accurate prints
Spores are the microscopic seeds of fungi, and capturing them is crucial for identification and study. One effective method to collect spore prints from Amanita mushrooms involves using glass or foil as a surface. This technique allows for a clean, undisturbed collection of spores overnight, ensuring an accurate and detailed print. By placing the mushroom cap, gills facing down, on a glass slide or a piece of aluminum foil, you create an ideal environment for spores to drop naturally. The smooth, non-porous surface of glass or foil prevents absorption, ensuring that the spores remain visible and intact for examination.
The process begins by selecting a mature Amanita mushroom with well-developed gills, as these are prime for spore release. Gently separate the cap from the stem, ensuring the gills remain undisturbed. Place the cap, gills down, onto the center of your chosen surface—glass for a transparent view or foil for flexibility and ease of handling. Cover the setup with a container, such as a glass jar or plastic cup, to maintain humidity and prevent contamination. Leave this undisturbed overnight, typically 8–12 hours, allowing gravity and time to facilitate spore drop. This method is particularly useful for species with delicate or slow-releasing spores, as it minimizes interference and maximizes collection efficiency.
While this method is straightforward, attention to detail is key. Ensure the collection surface is clean and free of debris to avoid confusing spores with foreign particles. Humidity is critical; if the environment is too dry, spore release may be hindered. Adding a few drops of water around the cap (not directly on it) can help maintain moisture without damaging the mushroom. For best results, perform this in a controlled environment, away from drafts or vibrations that could disrupt the process. This method is especially valuable for mycologists and enthusiasts seeking precise identification, as the clarity of the spore print can reveal characteristics like color, shape, and arrangement.
Comparing this method to others, such as using paper or cardboard, highlights its advantages. Porous materials like paper can absorb spores, making them less visible and harder to analyze. Glass and foil, however, provide a clear contrast, allowing for easy observation under a microscope or with the naked eye. Additionally, these materials are reusable, making them cost-effective and environmentally friendly. For those studying Amanita mushrooms, this collection method is not just practical but essential for obtaining reliable data. With patience and precision, it transforms a simple overnight setup into a powerful tool for fungal exploration.
Can Mold Spores Stick to Your Clothes? Facts and Prevention Tips
You may want to see also

Identification Tips: Spore print color is key for distinguishing Amanita from other fungi
Spore print color serves as a critical diagnostic feature for identifying Amanita mushrooms, setting them apart from other fungi with striking precision. Unlike the subjective nature of cap color or stem shape, which can vary due to environmental factors, spore print color remains consistent within species. For instance, most Amanita species produce white spore prints, a characteristic that sharply contrasts with the brown or black prints of Boletus or the purple prints of Cortinarius. This consistency makes spore printing an indispensable tool for both amateur foragers and mycologists alike.
To create a spore print, follow these steps: Place the cap of a mature Amanita mushroom gill-side down on a piece of white paper or glass for light-colored spores, or dark paper for white spores. Cover the cap with a bowl to retain moisture and prevent air currents from dispersing the spores. After 2–24 hours, carefully lift the cap to reveal a powdery deposit of spores. For Amanita, this deposit will typically be white, though exceptions like *Amanita muscaria* (white spores) and *Amanita ocreata* (white to cream) reinforce the rule. Always use a mature specimen, as young or old mushrooms may yield incomplete prints.
While spore print color is a reliable identifier, it’s not foolproof. Some non-Amanita species, such as certain Agaricus or Lepiota, also produce white spore prints, highlighting the need to cross-reference with other features like volva, bulb, or gill attachment. Additionally, environmental factors like humidity can affect print clarity, so consistency in technique is key. For example, a poorly sealed cap or insufficient time may result in a faint or incomplete print, leading to misidentification. Always verify results with multiple specimens if possible.
The analytical value of spore print color extends beyond identification—it also aids in understanding Amanita’s ecological role. As saprotrophs or mycorrhizal partners, their spore dispersal mechanisms are finely tuned to their habitats. White spores, for instance, are often adapted to forest floors where they blend with light-filtered environments, ensuring survival and propagation. This biological insight underscores why spore printing isn’t just a taxonomic exercise but a window into fungal ecology.
In conclusion, mastering spore print analysis is a cornerstone of Amanita identification, offering clarity in a kingdom of look-alikes. By combining this technique with other morphological observations, foragers can navigate the complexities of fungal diversity with confidence. Remember: a white spore print is a strong indicator of Amanita, but it’s the interplay of all features that confirms the identity. Approach each specimen with curiosity, precision, and respect for the intricate world of fungi.
Mold Spore Allergies: Breathing Challenges in Humid Environments Explained
You may want to see also
Explore related products

Environmental Factors: Humidity and temperature affect spore release and print clarity
Spore printing, a critical technique in mycology, relies heavily on environmental conditions to yield accurate and clear results. Among the most influential factors are humidity and temperature, which can either facilitate or hinder the release and deposition of spores from Amanita mushrooms. Understanding these dynamics is essential for anyone attempting to identify species through spore prints.
Optimal Conditions for Spore Release
Amanita mushrooms, like many fungi, release spores most effectively under specific humidity and temperature ranges. Ideal humidity levels typically fall between 80% and 95%, as this mimics the damp environments where these mushrooms naturally thrive. At this moisture level, the gills or pores of the Amanita are encouraged to discharge spores freely. Temperature also plays a pivotal role, with a range of 68°F to 75°F (20°C to 24°C) being most conducive to spore release. Outside these parameters, the mushroom may retain its spores or release them inconsistently, leading to incomplete or unclear prints.
The Impact of Humidity on Print Clarity
Humidity directly affects the clarity and uniformity of a spore print. Too little humidity can cause spores to dry out prematurely, resulting in a scattered or patchy print. Conversely, excessive humidity may lead to spore clumping or mold growth, obscuring the print’s detail. For best results, place the Amanita cap on a piece of glass or paper in a sealed container with a damp paper towel to maintain consistent moisture. This controlled environment ensures spores fall evenly, creating a sharp, distinct print.
Temperature’s Role in Spore Viability
Temperature not only influences spore release but also affects spore viability and print quality. Cooler temperatures below 60°F (15°C) can slow or halt spore discharge, while warmer temperatures above 80°F (27°C) may stress the mushroom, leading to irregular release patterns. For instance, a spore print taken in a warm, dry room may show gaps or streaks, making identification difficult. To mitigate this, work in a temperature-stable environment, such as a room with regulated climate control, or use a makeshift setup like a small cooler with a damp cloth to maintain optimal conditions.
Practical Tips for Success
To maximize the success of your spore print, monitor environmental conditions closely. Use a hygrometer to track humidity and a thermometer to gauge temperature. If natural conditions are unfavorable, create a microenvironment by placing the mushroom and collection surface inside a plastic bag or container with a damp paper towel. Allow 6 to 24 hours for spore release, checking periodically to ensure the print is developing evenly. Once complete, let the print dry undisturbed in a cool, dry place to preserve its clarity.
By mastering the interplay of humidity and temperature, you can significantly improve the reliability and quality of Amanita spore prints, turning a potentially frustrating process into a rewarding scientific endeavor.
Can Coffee Kill Spores? Uncovering the Truth Behind This Claim
You may want to see also

Toxicity Warning: Always verify species; some Amanita are deadly despite spore print similarities
Amanita mushrooms are notorious for their dual nature: some are prized for culinary use, while others are lethally toxic. A spore print—a method used to identify mushrooms by the color of their spores—is often relied upon by foragers. However, this technique falls short when distinguishing between deadly and edible Amanita species. For instance, the innocuous Amanita muscaria (fly agaric) and the deadly Amanita phalloides (death cap) both produce white spore prints, yet one is psychoactive and the other can cause liver failure within 48 hours of ingestion. This similarity underscores the danger of relying solely on spore prints for identification.
Foraging for mushrooms without proper knowledge is akin to playing Russian roulette with nature. Even experienced mycologists emphasize the importance of cross-referencing multiple identification features, such as cap color, gill structure, and habitat. A single misidentified Amanita can contain amatoxins, which are not destroyed by cooking or drying. Symptoms of poisoning—nausea, vomiting, diarrhea, and jaundice—often appear 6–24 hours after consumption, by which time irreversible organ damage may have begun. Immediate medical attention, including activated charcoal administration and, in severe cases, liver transplantation, is critical for survival.
Children and pets are particularly vulnerable due to their smaller body mass and tendency to explore outdoors. A single death cap mushroom contains enough toxins to kill an adult, and even smaller amounts can be fatal to a child or pet. Teaching children to "look but not touch" and securing outdoor areas to prevent pet ingestion are essential precautions. For adults, carrying a field guide or using a reputable mushroom identification app can provide an additional layer of safety, though these tools should never replace expert verification.
The allure of wild mushrooms often overshadows their potential peril. While spore prints are a useful tool, they are not a definitive identifier. Foraging should be approached with humility and caution, prioritizing safety over curiosity. Joining local mycological societies or attending workshops can provide hands-on learning and mentorship, reducing the risk of fatal mistakes. Remember: when in doubt, throw it out. The cost of misidentification is far too high to gamble with your life.
Are Glomeromycota Spores Multicellular? Unraveling the Fungal Mystery
You may want to see also
Frequently asked questions
No, not all Amanita mushrooms will drop a visible spore print. Factors like age, moisture, and species can affect whether a spore print is produced.
It typically takes 4 to 24 hours for an Amanita mushroom to drop a spore print, depending on humidity and the mushroom's maturity.
The spore print color varies by species. Common colors include white, cream, yellow, or even pinkish, depending on the Amanita type.
Yes, you can increase humidity by placing the mushroom cap on aluminum foil or glass and covering it with a container to encourage spore release.